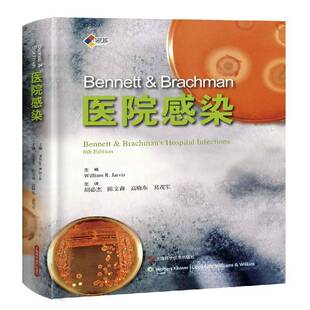
RT正版 Bent & Brachman医院感染9787547830475 上海科学技术出版社医药卫生书籍

ATOMIC阿托米克滑雪双板2425新品自由式BENT系列野雪粉雪公园板


42滑雪新款ATOMIC阿托米克自由式滑雪板双板BENT系列男女滑雪装备


ATOMIC阿托米克滑雪双板2526新品BENT系列野雪粉雪公园板Bent 85


ATOMIC阿托米克滑雪双板2526新品BENT系列野雪粉雪公园板Bent 90


ATOMIC阿托米克滑雪双板2526新品BENT*GFD联名款野雪自由式双板


ATOMIC阿托米克滑雪双板2526新品BENT系列自由式野雪板Bent 120


现货 Lana Del Rey 拉娜·德雷诗歌集 精装 打雷姐诗集 英文原版 Violet Bent Backwards Over the Grass 新书 雷姐诗集


JOJO'S L.PD.bent.酒具玻璃杯高颜值家用耐高温高硼硅丨尘曲


打雷姐诗集 打雷姐诗歌集 英文原版 Lana Del Rey Violet Bent Backwards Over the Grass 拉娜德雷 明星周边书 薇奥菈在草地嬉戏


现货 拉娜德雷诗歌集Violet Bent Backwards Over the Grass打雷姐书


如何完成大事 How Big Things Get Done 英文原版 Bent Flyvbjerg and Dan Gardner 经管励志 自我提升【中商原版】


Auramoon.Bent.鼠标垫创意木鱼异型女生护手腕办公室桌垫 | 趣怀


【现货】Economic Modeling and Inference 经济建模与推理 Bent Jesper Christensen & Nicholas M. Kiefer 精装版


陶瓷烧烤炉配件不锈钢肋排烤架 户外BBQ大排肋骨烤肉支架Rib bent


MOLA.Bent.纸巾盒客厅轻奢风高档设计感茶几抽纸盒摆件 | 序曲


MOLA.Bent.纸巾盒客厅轻奢风高档设计感茶几抽纸盒摆件 | 序曲


MOLA.Bent.纸巾盒客厅轻奢风高档设计感茶几抽纸盒摆件 | 序曲

RT正版 Bent & Brachman医院感染9787547830475 上海科学技术出版社医药卫生书籍


美国原产Xuron系列细弯嘴钳Bent Nose PliJer Cutter手工DIY造型


Insulated Lunch Box Handbag for Office Workers, Thermal Bent


Japanese-style bent-head toilet brush with soft bristles and


BenT-CNC微电脑控制器:BR010-11T8X2M,拆


Auramoon.Bent.饭盒幼儿便携外出辅食盒水果盒可分格便当 | 此曲


Auramoon.Bent.干发帽女超强吸水速干洗头包头发毛巾浴帽 | 曲声


Auramoon.Bent.雨伞高颜值太阳伞女防晒防紫外线折叠晴雨伞 |曾曲


肆加贰雪具库新款ATOMIC阿托米克双板自由式滑雪板BENT系列装备


AZEREI新款ATOMIC阿托米克双板自由式滑雪板BENT系列滑雪装备


Get Bent Gumby T-Shirt小绿人冈比动画片复古男女款纯棉短袖T恤


BENT IDEA 2024夏季新款男士立体钢印潮流麂皮绒短袖休闲大码T恤


BENT IDEA条纹短袖T恤男夏季新款质感cleanfit刺绣圆领半袖体恤衫


BENT IDEA 2024夏季新款260克重磅圆领前后丝网印花短袖休闲T恤男


BENT IDEA2025夏季款美式字母印花半袖短袖T恤潮牌宽松情侣体恤衫


冷山雪具双板ATOMIC双板自由式滑雪板BENT系列滑雪含固定器2526款


冷山双板ATOMIC阿托米克双板自由式滑雪板BENT系列滑雪含固定器25


BENT IDEA 冬季新款休闲宽松潮流冲锋衣可脱卸内胆90白鸭绒羽绒服


现货 打雷姐诗集 拉娜·德雷诗歌集 英文原版 Lana Del Rey 精装 Violet Bent Backwards Over the Grass 美国 歌手 打雷姐新书


Yoga Wheel Bent Back Stretch Natural Cork Solid Fitness


OMFB斜轴柱塞泵BENT-AXIS TFP53/53 SX 108-030-00514 液压马达


OMFB斜轴柱塞泵BENT-AXIS TFP53/53 SX 108-030-00514 液压马达


OMFB斜轴柱塞泵BENT-AXIS TFP53/53 SX 108-030-00514 液压马达

